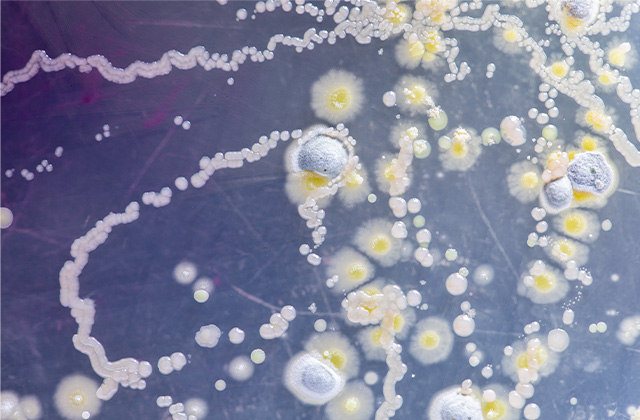

食中毒とは
食中毒とは、食中毒の原因となる細菌やウイルス、有毒物質などを食べ物と一緒に摂取することで、下痢や腹痛、発熱、嘔吐などの健康被害が起こることです。
食中毒の原因によって、症状や食べてから症状が出るまでの期間は様々です。
食中毒の原因
食中毒の病因物質は、細菌、寄生虫、ウイルス、自然毒、化学物質など様々です。
-
細菌
-

ウイルス
-

寄生虫
-

動物性自然毒
-

植物性自然毒
-

化学物質
発生が多い食中毒
-

カンピロバクター
カンピロバクターは、ニワトリやウシ、ブタ等の家畜・家きん類の腸管内に生息している菌であり、半生や加熱が不十分な食肉(特に鶏肉)やレバー(鶏、豚、牛)などの臓器を食べたり、カンピロバクターに汚染された飲料水などを飲むことにより食中毒を引き起こします。
-

ノロウイルス
ノロウイルスによる食中毒は、一年をとおして発生していますが、特に冬に流行しています。ノロウイルスは、少量でも手指や食品などを介して口から感染(経口感染)し、食中毒を引き起こします。調理従事者がノロウイルスを保有していて、調理や配膳過程において食品を汚染してしまい、その食品を食べることにより二次的に食中毒を起こすことがあります。
-

アニサキス
アニサキスは寄生虫(線虫)の一種で、その幼虫(アニサキス幼虫)はサバ、アジ、サンマ、カツオ、イワシ、サケ、イカなどの魚介類に寄生します。アニサキス幼虫が寄生している生鮮魚介類を生で食べることで、 アニサキス食中毒を引き起こします。

予防方法
食中毒予防の3原則は、細菌やウイルスを①つけない②増やさない③やっつけるです。
家庭でできる食中毒予防の6つのポイントを紹介します。
食中毒予防の3原則
-
菌やウイルスを食べ物につけない
-
食べ物に付着した菌などを増やさない
-
食べ物や調理器具に付着した
菌やウイルスをやっつける
家庭でできる食中毒予防の
6つのポイント
-
食品の購入
消費期限等を確認しましょう。

-
家庭での保存
冷蔵や冷凍の必要な食品は冷蔵庫や冷凍庫に入れましょう。

-
下準備
調理の前は手を洗いましょう。

-
調理
加熱して調理する食品は十分に加熱しましょう。

-
食事
調理後の食品は、室温に長く放置しないようにしましょう。

-
残った食品
ちょっとでも怪しいと思ったら、口に入れるのはやめましょう。

食中毒かも?と思ったら
- できるだけ早く医療機関を受診しましょう。
- お住まいの地域の保健所に相談しましょう。
-
保健所設置市の担当窓口
横浜市、川崎市、相模原市、
横須賀市、藤沢市、 茅ヶ崎市(寒川町を含む) -
保健福祉事務所の担当窓口
保健所設置市以外の
市町村
食中毒について
もっと知りたい方は
よくある質問
細菌とウイルスの違いは何ですか?
細菌は単細胞の生物であり、自ら細胞分裂により増殖します。一方、ウイルスは他の生物の細胞に入り、その中でだけ増殖します。
食中毒の原因となる菌やウイルスを摂取したら、すぐに食中毒の症状がでるのですか?
食中毒の原因となる菌やウイルスに感染してから症状が発現するまでの期間を「潜伏期間」といいます。潜伏期間は原因となる食中毒菌やウイルスにより異なります。数時間で症状が出るものもあれば、一週間以上経ってから症状が出るものもあります。
神奈川県の食中毒の発生状況を知りたい。
神奈川県内全体(県・保健所設置市六市を含む)の食中毒発生状況はこちらをご覧ください。
- TOP
- 食中毒





